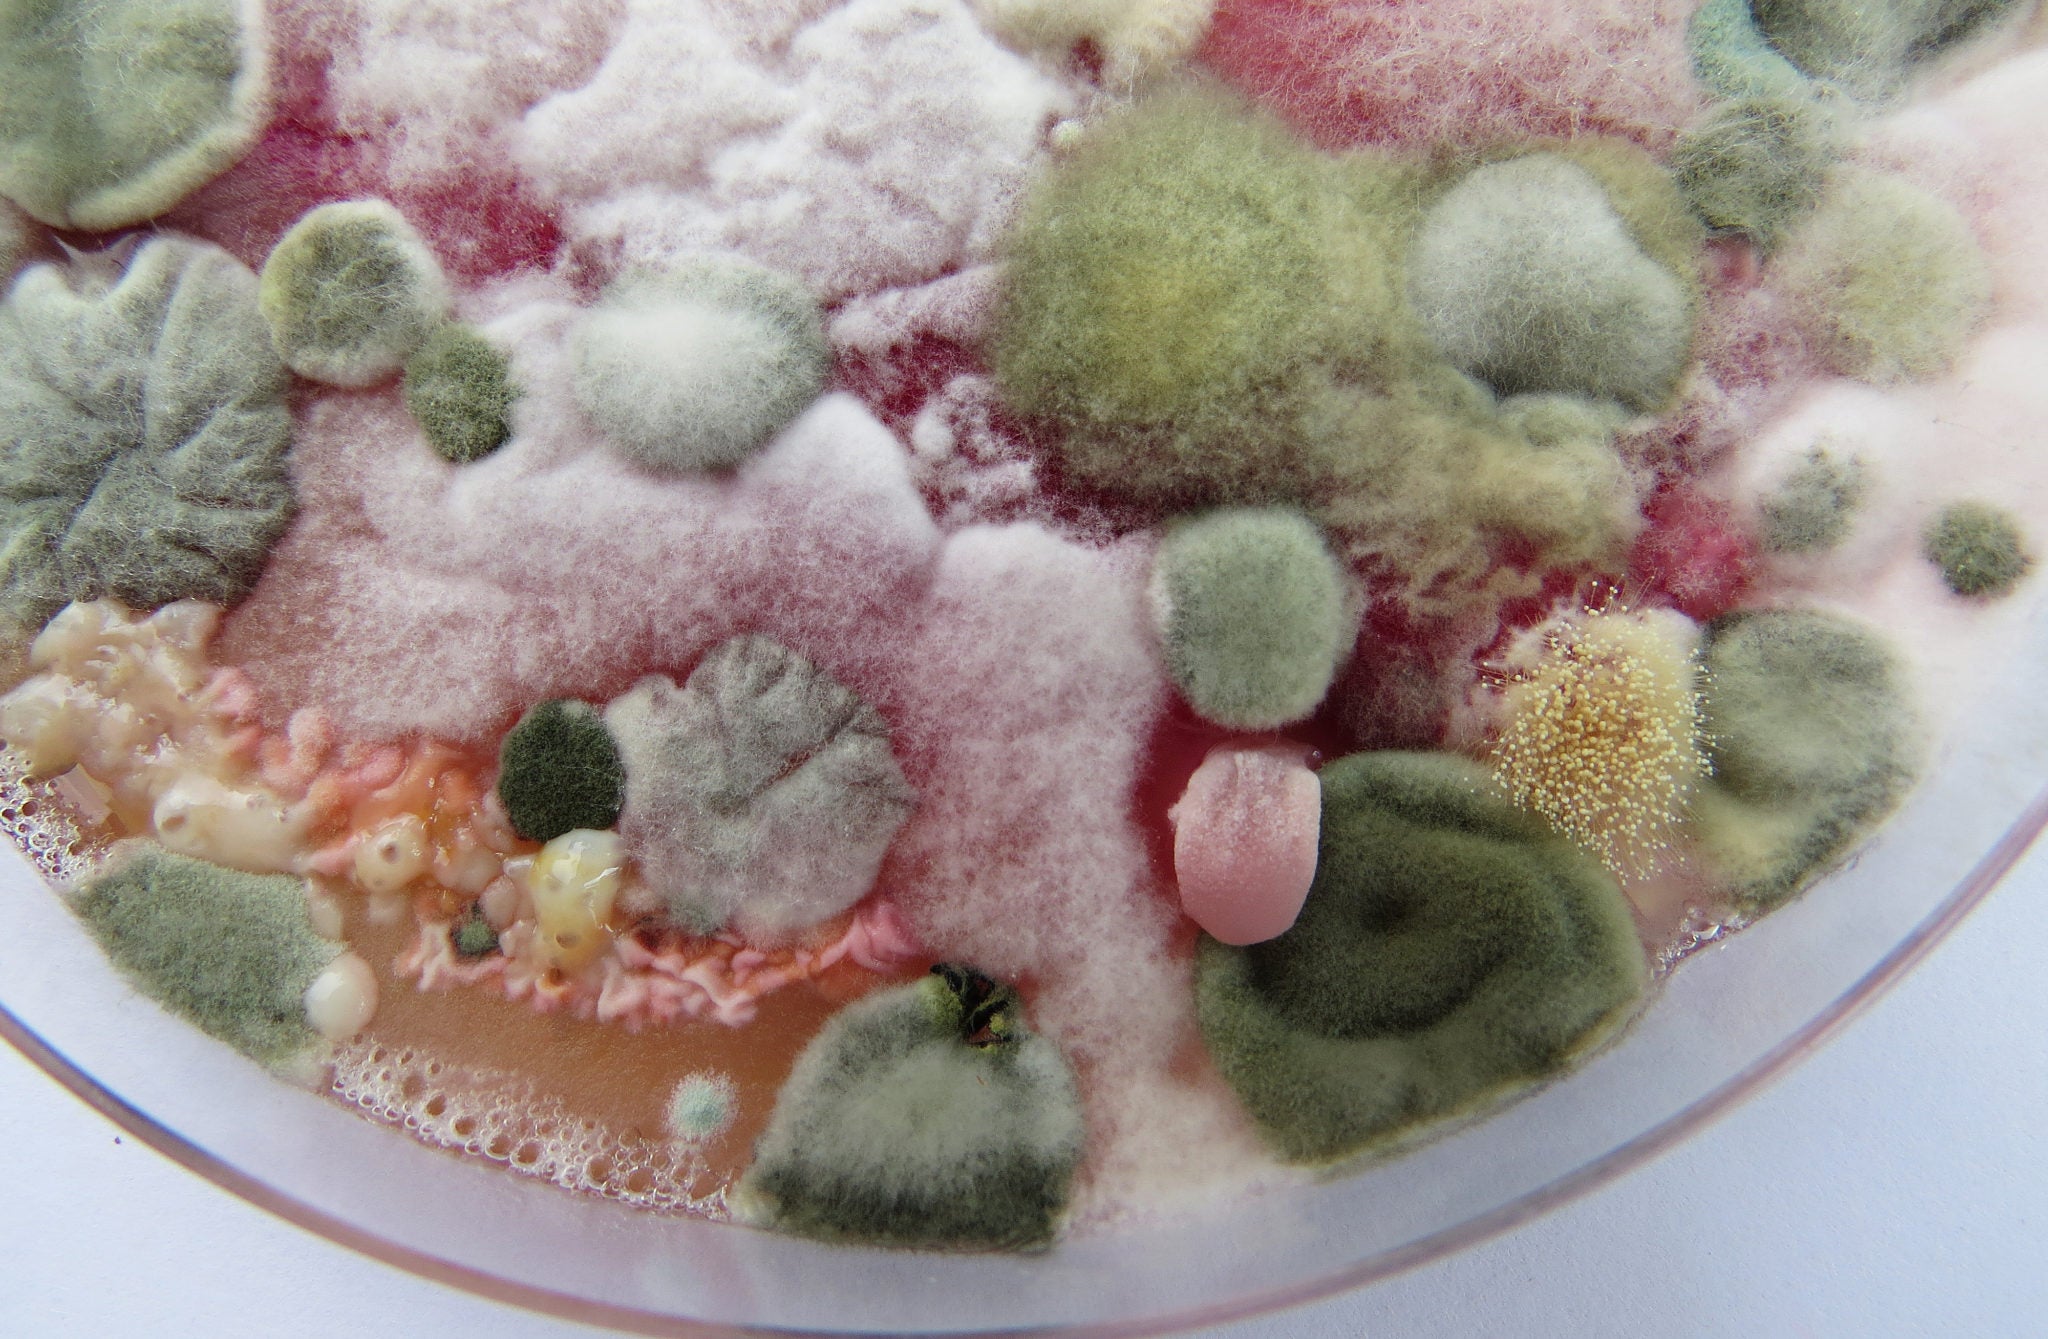
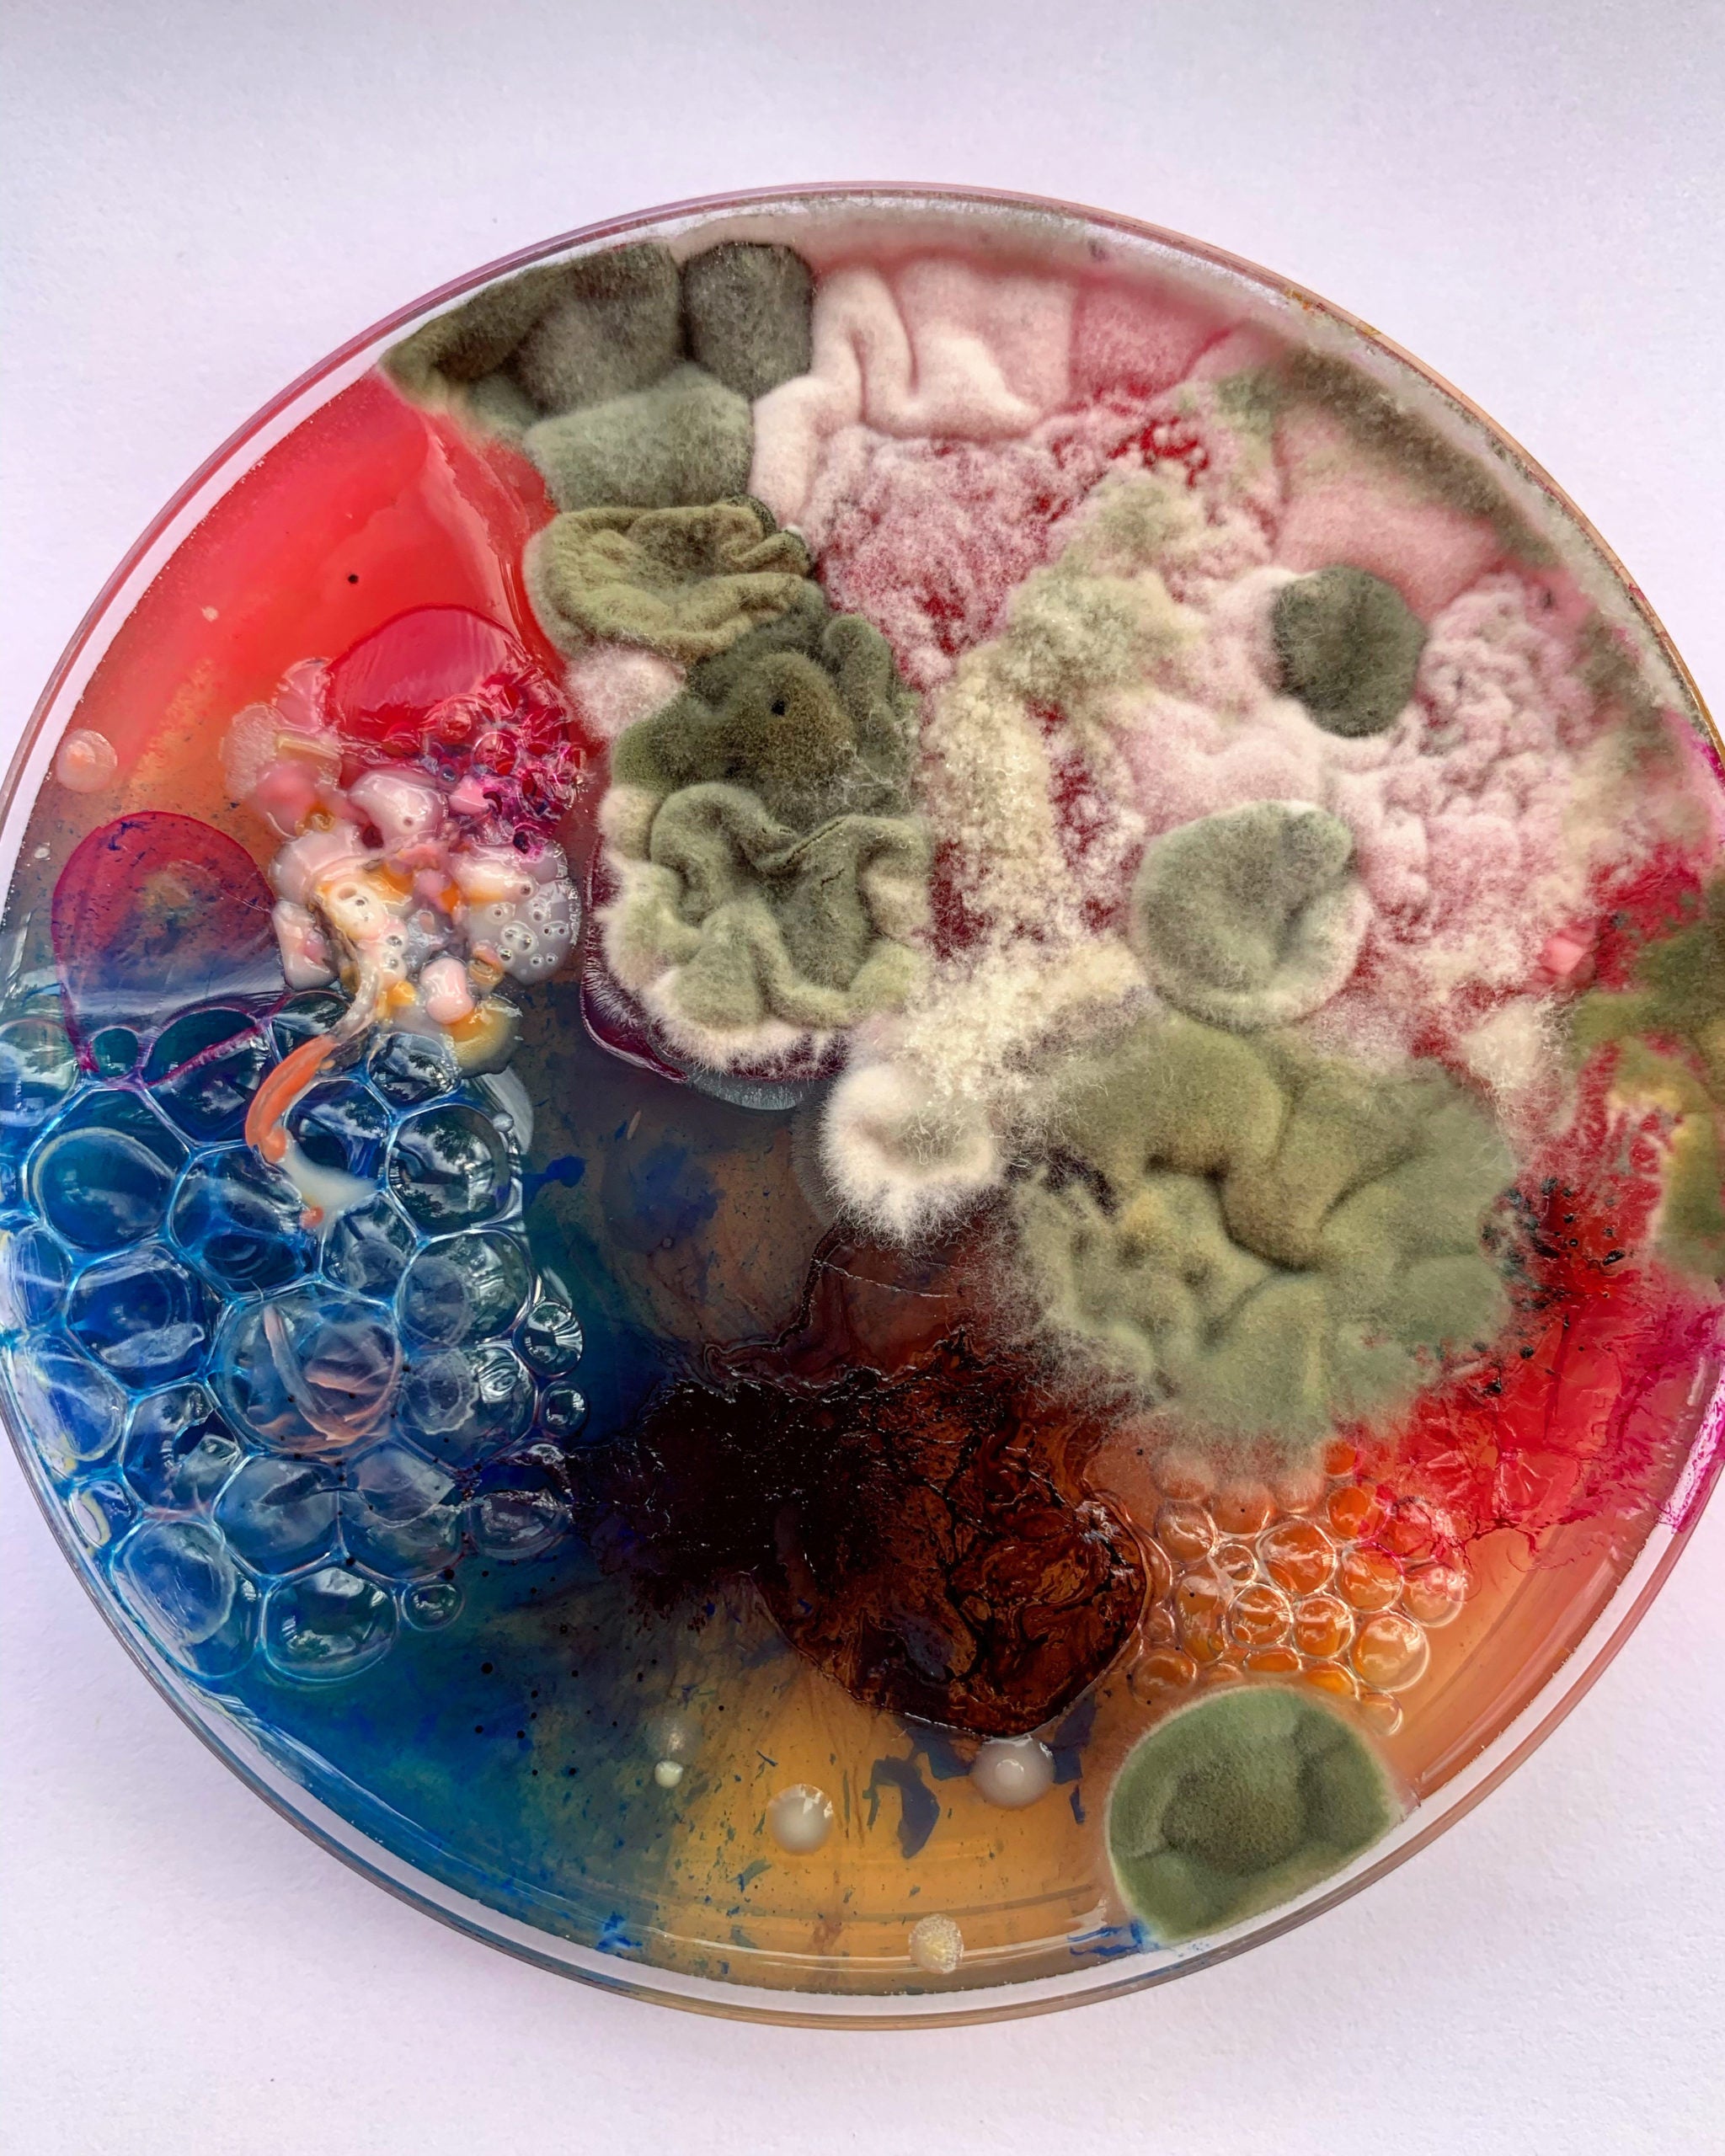

The Art of the Microbiome – Our Collaboration with Dasha Plesen
Share article
The images shown on the sleeves of our gift sets are macro photographs taken of Petri dishes swabbed with parts of the body and face. These pieces of art were grown by artist Dasha Plesen, who created them from the many microorganisms that are present on our skin. Each Petri dish is tended to in conditions that catalyse growth, resulting in an array of forms and colours at different stages of the growth cycle.

Artist Dasha Plesen (Daria Fedorova) is a Moscow-based artist with a love of microbiological mapping. Her love for microbial art began 7 years ago when she was studying her foundation art and design course. The idea began as a microbiological map, showing all the organisms we come into contact with throughout the day. Including every surface within our homes and when being around others. Since then she is still in disbelief when each Petri dish she creates comes out with all new textures, colours and forms. Her work allows us to see what is invisible to the human eye by bringing it to life through the medium of art.
Dasha’s work focuses on the process of “seeding”. Her pieces can be seen as performance art as she collects microorganisms from all around her, including the air, and everyday objects, sometimes even from her own body. These are then swabbed onto her nutrient canvas, usually in the form of a Petri dish. The set of images that she creates isn’t always the final pieces as her living work has been showcased, along with some textiles made from the images.


The microbiome is a representation of being, the earth and all around us. Dasha believes that this invisible world that lives on our skin and within us is critical to life, and can affect us in many different ways. Even the smell of our skin, mouth and hair is all dictated by our “biocode”. Each of her pieces contains organisms that vary immensely. This is not only because of who the swabs are taken from, but also where on the body and when it was taken, as seasons can even change the organisms that grow on our body.
The process is similar to preparing a canvas, but this can take many forms. It begins by filling Petri dishes with a nutrient solution that she cooks in her kitchen. But this nutrient can also be shaped into forms using moulds. Or it can even be used as a paint for use on fabrics and printed images. Then “ingredients” are added to the nutrient, which could include spices or food, but also can include the introduction of yeasts, foodstuff, and biofilms. But Dasha often uses paints and inks to give the pieces contrasting colours when the microorganisms begin to grow. Samples are then taken from her collection of organisms, or swabs directly off the skin. These swabs are rubbed onto the medium and then each one is allowed to grow freely from anywhere between two to six weeks. Controlled environments are key to optimal growth. It is important to keep temperatures the same as where the organisms would naturally grow. For example, if the swabs were taken from the skin it would need to be body temperature. As the organisms are allowed to grow with little control, the results vary depending on how they interact with one another, how they react to the environment, and whether any contamination is present.

Highlighting the complexity and symbiosis of our skin’s microbiome is vital to us. The images on our sleeves highlight just some of the trillions of bacteria and fungi that compose the microbiota on the various layers of our skin. Each person’s microbiome is unique, but environmental factors and what we put on our skin can impact the amount of different microorganisms, causing dysbiosis or an imbalance. Seeing our skin as a living ecosystem allows us to understand the importance of taking care of our skin and the impact that our skincare can have on its health.
As a business, we created Haeckels Lab skincare, a skincare suite certified as Kind to Biome, using lab-grown renewable resources. You can explore Haeckels Lab here:


With special thanks to Dasha Plesen
..
Find more out about her work here
+ Dasha’s instagram is @dashaplesen


